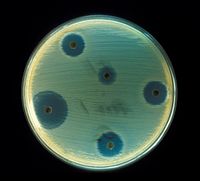
Testing the susceptibility of Staphylococcus aureus to antibiotics by the Kirby-Bauer disk diffusion method. Antibiotics diffuse out from antibiotic-containing disks and inhibit growth of S. aureus resulting in a zone of inhibition.

Antibiotic
2008/9 Schools Wikipedia Selection. Related subjects: Health and medicine
The term antibiotic (from Greek αντί - anti, "against" + βιοτικός - biotikos, "fit for life") was coined by Selman Waksman in 1942, to refer to any substance produced by a micro-organism that is antagonistic to the growth of others in high dilution (which therefore excludes other naturally occurring substances such as gastric juice and hydrogen peroxide). The strict definition therefore excludes synthetic compounds such as the sulphonamides (which are antimicrobial agents). In modern usage, the term "antibiotic" is now also more loosely used to refer to any chemotherapeutic agent or antimicrobial agent with activity against micro-organisms (bacteria, fungi, protozoa).
Many antibiotic compounds used in modern medicine are produced and isolated from living organisms, such as the penicillin class produced by fungi in the genus Penicillium, or streptomycin from bacteria of the genus Streptomyces. With advances in medicinal chemistry many antibiotics are now modified chemically from their original form found in nature. In addition, some modern antibiotics have been created through purely synthetic means. Many antibiotics are relatively small molecules with a molecular weight less than 2000 Da.
Overview
Unlike previous treatments for infections, which often consisted of administering chemical compounds such as strychnine and arsenic, with high toxicity also against mammals, antibiotics from microbes had no or few side effects and high effective target activity. Most anti-bacterial antibiotics do not have activity against viruses, fungi, or other microbes. Anti-bacterial antibiotics can be categorized based on their target specificity: "narrow-spectrum" antibiotics target particular types of bacteria, such as Gram-negative or Gram-positive bacteria, while broad-spectrum antibiotics affect a wide range of bacteria.
The environment of individual antibiotics varies with the location of the infection, the ability of the antibiotic to reach the site of infection, and the ability of the microbe to inactivate or excrete the antibiotic. Some anti-bacterial antibiotics destroy bacteria (bactericidal), whereas others prevent bacteria from multiplying (bacteriostatic).
Oral antibiotics are simply ingested, while intravenous antibiotics are used in more serious cases, such as deep-seated systemic infections. Antibiotics may also sometimes be administered topically, as with eye drops or ointments.
In the last few years three new classes of antibiotics have been brought into clinical use. This follows a 40-year hiatus in discovering new classes of antibiotic compounds. These new antibiotics are of the following three classes: cyclic lipopeptides (daptomycin), glycylcyclines (tigecycline), and oxazolidinones (linezolid). Tigecycline is a broad-spectrum antibiotic, while the two others are used for gram-positive infections. These developments show promise as a means to counteract the growing bacterial resistance to existing antibiotics.
History
Although potent antibiotic compounds for treatment of human diseases caused by bacteria (such as tuberculosis, bubonic plague, or leprosy) were not isolated and identified until the twentieth century, the first known use of antibiotics was by the ancient Chinese over 2,500 years ago. Many other ancient cultures, including the ancient Egyptians, ancient Greeks and medieval Arabs already used molds and plants to treat infections, owing to the production of antibiotic substances by these organisms, a phenomenon known as antibiosis Antibiosis was first described in 1877 in bacteria when Louis Pasteur and Robert Koch observed that an airborne bacillus could inhibit the growth of Bacillus anthracis. The antibiotic properties of Penicillium sp. were first described in France by Ernest Duchesne in 1897. However, his work went by without much notice from the scientific community until Alexander Fleming's discovery of Penicillin (see below).
Modern research on antibiotic therapy began in Germany with the development of the narrow-spectrum antibiotic Salvarsan by Paul Ehrlich in 1909, for the first time allowing an efficient treatment of the then-widespread problem of Syphilis. The drug, which was also effective against other spirochaetal infections, is no longer in use in modern medicine.
Antibiotics were further developed in Britain following the discovery of Penicillin in 1928 by Alexander Fleming. More than ten years later, Ernst Chain and Howard Florey became interested in his work, and came up with the purified form of penicillin. The three shared the 1945 Nobel Prize in Medicine. In 1939, Rene Dubos isolated gramicidin, one of first antibiotics to be manufactured commercially used during World War II proving highly effective in the treatment of wounds and ulcers.. Florey credited Dubos for reviving his research on penicillin
"Antibiotic" was originally used to refer only to substances extracted from a fungus or other microorganism, but has come to also include the many synthetic and semi-synthetic drugs that have antibacterial effects. Antibiotics can help succeed in curing many illnesses.
Classes of antibiotics
At the highest level, antibiotics can be classified as either bactericidal or bacteriostatic. Bactericidals kill bacteria directly where bacteriostatics prevent them from dividing. However, these classifications are based on laboratory behaviour; in practice, both of these are capable of ending a bacterial infection.
Production
Since the first pioneering efforts of Florey and Chain in 1939, the importance of antibiotics to medicine has led to much research into discovering and producing them. The process of production usually involves screening of wide ranges of microorganisms, testing and modification. Production is carried out using fermentation, usually in strongly aerobic fermentation.
Usage
Antibiotics are only intended to be used by a doctor's prescription. Doctors always specify dosage and duration of antibiotic treatment. It is very important to follow the prescription and complete the entire course (see Antibiotic misuse).
In general, alcohol should be avoided when taking antibiotics as it causes a variety of things to happen in the body, and some of them can impair the effectiveness of antibiotics; It also competes with liver enzymes, which break down the antibiotics. Additionally, certain antibiotics including Metronidazole, Tinidazole, co-trimoxazole, cephamandole, ketoconazole chemically react with alcohol, leading to serious body reactions (severe vomiting, nausea, etc.). Such antibiotics are explicitly prohibited to be used with alcohol.
Side effects
Possible side effects are varied, depending on the antibiotics used and the microbial organisms targeted. Adverse effects can range from fever and nausea to major allergic reactions including photodermatitis. One of the more common side effects is diarrhea, sometimes caused by the anaerobic bacterium Clostridium difficile, which results from the antibiotic disrupting the normal balance of the intestinal flora, Such overgrowth of pathogenic bacteria may be alleviated by ingesting probiotics during a course of antibiotics.. An antibiotic-induced disruption of the population of the bacteria normally present as constituents of the normal vaginal flora may also occur, and may lead to overgrowth of yeast species of the genus Candida in the vulvo-vaginal area. Other side effects can result from interaction with other drugs, such as elevated risk of tendon damage from administration of a quinolone antibiotic with a systemic corticosteroid.
Hypothetically, some antibiotics might interfere with the efficiency of birth control pills. However there have been no conclusive studies that proved that; on the contrary, the majority of the studies indicate that antibiotics do not interfere with contraception, even though there is a possibility that a small percentage of women may experience decreased effectiveness of birth control pills while taking an antibiotic.
Antibiotic misuse
Common forms of antibiotic misuse include failure to take the entire prescribed course of the antibiotic, or failure to rest for sufficient recovery to allow clearance of the infecting organism. These practices may facilitate the development of bacterial populations with antibiotic resistance. Inappropriate antibiotic treatment is another common form of antibiotic misuse. A common example is the prescription and use of antibiotics to treat viral infections such as the common cold that have no effect.
Animals
It is estimated that greater than 70% of the antibiotics used in U.S. are given to feed animals (e.g. chickens, pigs and cattle) in the absence of disease. Antibiotic use in food animal production has been associated with the emergence of antibiotic-resistant strains of bacteria including Salmonella spp., Campylobacter spp., Escherichia coli, and Enterococcus spp. Evidence from some US and European studies suggest that these resistant bacteria cause infections in humans that do not respond to commonly prescribed antibiotics. In response to these practices and attendant problems, several organizations (e.g. The American Society for Microbiology (ASM), American Public Health Association (APHA) and the American Medical Association (AMA)) have called for restrictions on antibiotic use in food animal production and an end to all non-therapeutic uses. However, delays in regulatory and legislative actions to limit the use of antibiotics are common, and may include resistance to these changes by industries using or selling antibiotics, as well as time spent on research to establish causal links between antibiotic use and emergence of untreatable bacterial diseases. Today, there are two federal bills (S.742 and H.R. 2562) aimed at phasing out non-therapeutic antibiotics in US food animal production. These bills are endorsed by public health and medical organizations including the American Nurses Association (ANA), the American Academy of Pediatrics (AAP), and the American Public Health Association (APHA).
Humans
One study on respiratory tract infections found "physicians were more likely to prescribe antibiotics to patients who they believed expected them, although they correctly identified only about 1 in 4 of those patients". Multifactorial interventions aimed at both physicians and patients can reduce inappropriate prescribing of antibiotics. Delaying antibiotics for 48 hours while observing for spontaneous resolution of respiratory tract infections may reduce antibiotic usage; however, this strategy may reduce patient satisfaction.
Excessive use of prophylactic antibiotics in travelers may also be classified as misuse.
Antibiotic resistance
Use or misuse of antibiotics may result in the development of antibiotic resistance by the infecting organisms, similar to the development of pesticide resistance in insects. Evolutionary theory of genetic selection requires that as close as possible to 100% of the infecting organisms be killed off to avoid selection of resistance; if a small subset of the population survives the treatment and is allowed to multiply, the average susceptibility of this new population to the compound will be much less than that of the original population, since they have descended from those few organisms that survived the original treatment. This survival often results from an inheritable resistance to the compound that was infrequent in the original population, but became more frequent in the descendants.
Antibiotic resistance has become a serious problem in both developed and underdeveloped nations. By 1984 half of those with active tuberculosis in the United States had a strain that resisted at least one antibiotic. In certain settings, such as hospitals and some childcare locations, the rate of antibiotic resistance is so high that the usual, low-cost antibiotics are virtually useless for treatment of frequently seen infections. This leads to more frequent use of newer and more expensive compounds, which in turn leads to the rise of resistance to those drugs. A struggle to develop new antibiotics ensues to prevent losing future battles against infection. To date, tuberculosis and pneumococcus are prominent examples of once easily treated infections where drug-resistance has become a problem.
Another example of selection is Staphylococcus aureus ('golden staph'), which could be treated successfully with penicillin in the 1940s and 1950s. At present, nearly all strains are resistant to penicillin, and many are resistant to nafcillin, leaving only a narrow selection of drugs such as vancomycin useful for treatment. The situation is complicated by the fact that genes coding for antibiotic resistance can be transferred between bacteria via plasmids, making it possible for bacteria never exposed to an antibiotic to acquire resistance from those which have. The problem of antibiotic resistance is made more widespread when antibiotics are used to treat disorders in which they have no efficacy, such as the common cold or other viral complaints, and when they are used broadly as prophylaxis rather than treatment (as in, for example, animal feeds), because this exposes more bacteria to selection for resistance.
Resistance modifying agents
One solution to combat resistance currently being researched is the development of pharmaceutical compounds that would revert multiple antibiotic resistance. These so called resistance modifying agents may target and inhibit MDR mechanisms, rendering the bacteria susceptible to antibiotics to which they were previously resistant. These compounds targets include among others
- Efflux inhibition(Phe-Arg-β-naphthylamide)
- Beta Lactamase inhibitors - Including Clavulanic acid and Sulbactam
Beyond antibiotics
The comparative ease of identifying compounds which safely cured bacterial infections was more difficult to duplicate in treatments of fungal and viral infections. Antibiotic research led to great strides in the knowledge of biochemistry, establishing large differences between the cellular and molecular physiology of the bacterial cell and that of the mammalian cell. This explained the observation that many compounds that are toxic to bacteria are non-toxic to human cells. In contrast, the basic biochemistries of the fungal cell and the mammalian cell are much more similar. This restricts the development and use of therapeutic compounds that attack a fungal cell, while not harming mammalian cells. Similar problems exist in antibiotic treatments of viral diseases. Human viral metabolic biochemistry is very closely similar to human biochemistry, and the possible targets of antiviral compounds are restricted to very few components unique to a mammalian virus.
Research into bacteriophages for use as antibiotics is presently ongoing. Several types of bacteriophage appear to exist that are specific for each bacterial taxonomic group or species. Research into bacteriophages for medicinal use is just beginning, but has led to advances in microscopic imaging. While bacteriophages provide a possible solution to the problem of antibiotic resistance, there is no clinical evidence yet that they can be deployed as therapeutic agents to cure disease.
Phage therapy has been used in the past on humans in the US and Europe during the 1920s and 1930s, but these treatments had mixed results. With the discovery of penicillin in the 1940s, Europe and the US changed therapeutic strategies to using antibiotics. However, in the former Soviet Union phage therapies continued to be studied. In the Republic of Georgia, the Eliava Institute of Bacteriophage, Microbiology & Virology continues to research the use of phage therapy. Various companies and foundations in North America and Europe are currently researching phage therapies. However, phage are living and reproducing; concerns about genetic engineering in freely released viruses currently limit certain aspects of phage therapy.
Bacteriocins are also a growing alternative to the classic small-molecule antibiotics . Different classes of bacteriocins have different potential as therapeutic agents. Small molecule bacteriocins ( microcins, for example, and lantibiotics) may be similar to the classic antibiotics; colicin-like bacteriocins are more likely to be narrow-spectrum, demanding new molecular diagnostics prior to therapy but also not raising the spectre of resistance to the same degree. One drawback to the large molecule antibiotics is that they will have relative difficulty crossing membranes and travelling systemically throughout the body. For this reason, they are most often proposed for application topically or gastrointestinally. Because bacteriocins are peptides, they are more readily engineered than small molecules. This may permit the generation of cocktails and dynamically improved antibiotics that are modified to overcome resistance.
Probiotics are another alternative that goes beyond traditional antibiotics by employing a live culture which may establish itself as a symbiont, competing, inhibiting, or simply interfering with colonization by pathogens. It may produce antibiotics or bacteriocins, essentially providing the drug in vivo and in situ, potentially avoiding the side effects of systemic administration.


